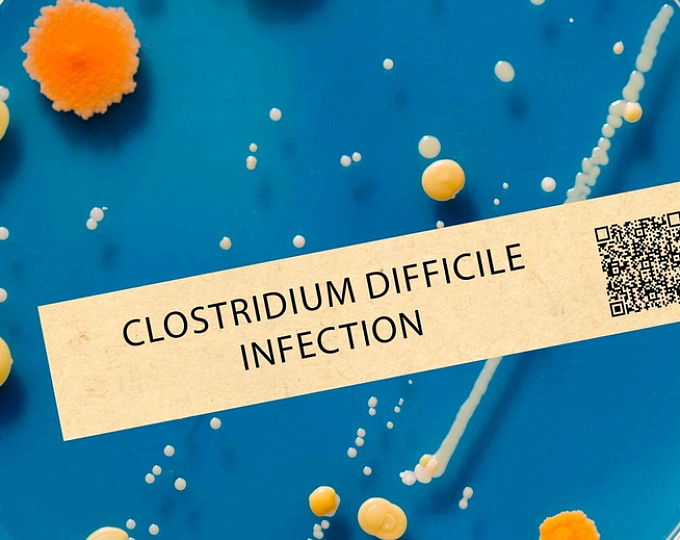
Сравнение риска инфекции Clostridium difficile на фоне антисекреторных препаратов

Актуальность
Антисекреторная терапия ингибиторами протонной помпы ассоциирована с повышением риска инфекции Clostridium difficile согласно данным наблюдательных исследований.
Целью исследования было оценить риск развития инфекции Clostridium difficile при применении нового класса антисекреторных препаратов — калий-конкурентных блокаторов протонной помпы.
Дизайн исследования
Группа корейских исследователей выполнила ретроспективное когортное исследование на основе электронных медицинских карт из 15 медицинских центров.
В исследование были включены пациенты, которым впервые назначались H2-блокаторы, ингибиторы протонной помпы или калий-конкурентные блокаторы протонной помпы.
В качестве первичной конечной точки рассматривалось развитие инфекции Clostridium difficile.
Результаты
Исследователи сравнили риск развития клостридиальной инфекции в следующих когортах:
- 61 596 пациентов, получавших калий-конкурентные блокаторы протонной помпы (средняя продолжительность наблюдения — 72,6 ± 29,9 дня), и 132 683 пациента, получавших ингибиторы протонной помпы (74,9 ± 28,6 дня);
- 42 794 пациента, получавших калий-конкурентные блокаторы протонной помпы (69,5 ± 32,4 дня), и 89 415 пациентов, получавших H2-блокаторы (69,9 ± 33,1 дня);
- 85 686 пациентов, получавших ингибиторы протонной помпы (71,1 ± 31,2 дня), и 159 178 пациентов, получавших H2-блокаторы (68,0 ± 33,8 дня).
Не выявлено статистически значимых различий между группами по частоте развития инфекции Clostridium difficile:
- отношение рисков (HR) составило 0,87 (95% ДИ 0,69–1,10) для калий-конкурентных блокаторов протонной помпы по сравнению с ингибиторами протонной помпы;
- 0,85 (95% ДИ 0,64–1,12) — по сравнению с H2-блокаторами;
- 1,13 (95% ДИ 0,98–1,29) — для ингибиторов протонной помпы по сравнению с H2-блокаторами.
Заключение
Согласно результатам исследования, антисекреторные препараты — калий-конкурентные блокаторы протонной помпы, ингибиторы протонной помпы и H2-блокаторы — ассоциированы с сопоставимым риском развития инфекции Clostridium difficile.
Источник: Lim Gyeongmin, Shin Ju-Young, Hyeon Da Eun, et al. Comparative safety of Potassium-competitive acid blockers on the risk of clostridium difficile infection: a multicenter cohort study. The American Journal of Gastroenterology ():10.14309/ajg.0000000000004011, March 31, 2026.